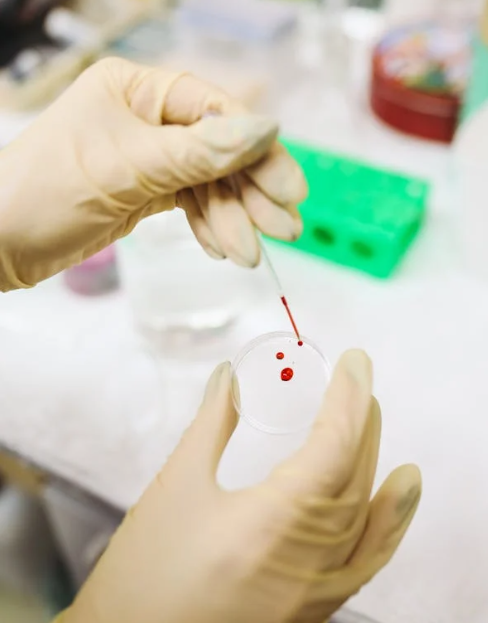

목차
현대인은 건강을 지키기 위해 정기적으로 건강검진을 받습니다. 그중 혈액검사는 간편하면서도 다양한 건강 정보를 얻을 수 있는 필수 항목입니다. 이 글에서는 혈액검사의 주요 항목과 각각의 의미, 정상 수치, 검사로 알 수 있는 질환까지 구체적으로 설명해 드립니다.

혈액검사란?
혈액검사는 혈액 속 성분을 분석하여 건강 상태를 평가하는 검사입니다. 간 기능, 신장 기능, 혈당, 지질, 빈혈, 염증 여부, 감염 등 다양한 질환의 조기 진단과 관리에 활용됩니다. 특히 건강검진, 병원 진료 전 검사, 만성질환 관리 등에서 필수로 시행됩니다.
주요 혈액검사 항목과 정상 수치
① CBC (전혈구 검사)
- 검사 목적: 빈혈, 감염, 백혈병 등 확인
- 항목 구성: 백혈구(WBC), 적혈구(RBC), 헤모글로빈(Hb), 헤마토크릿(Hct), 혈소판(Platelet)
- 정상 수치 예시
- 백혈구: 4,000~10,000/µL
- 혈소판: 150,000~400,000/µL
② 간기능 검사 (LFT)
- 검사 목적: 간염, 간 기능 저하 여부 확인
- 주요 항목
- AST (GOT), ALT (GPT), ALP, 총 빌리루빈
- 정상 수치
- AST, ALT: 0~40 IU/L
- ALP: 44~147 IU/L
- 총 빌리루빈: 0.3~1.2 mg/dL
③ 신장기능 검사
- 검사 목적: 신장 손상 여부 확인
- 주요 항목
- BUN, Creatinine, eGFR
- 정상 수치
- BUN: 7~20 mg/dL
- 크레아티닌: 남성 0.7
1.3 / 여성 0.61.1 mg/dL - eGFR: 60 이상이 정상
④ 혈당 검사
- 검사 목적: 당뇨병 여부 확인
- 항목
- 공복혈당, 당화혈색소(HbA1c)
- 정상 수치
- 공복혈당: 70~99 mg/dL
- HbA1c: 5.7% 이하
⑤ 지질 검사 (Lipid profile)
- 검사 목적: 고지혈증, 심혈관질환 위험도 평가
- 항목
- 총 콜레스테롤, LDL, HDL, 중성지방
- 정상 수치
- 총 콜레스테롤: <200 mg/dL
- LDL: <100 mg/dL
- HDL: >40 mg/dL
- 중성지방: <150 mg/dL
⑥ 전해질 검사
- 검사 목적: 탈수, 전해질 불균형 확인
- 항목: 나트륨(Na), 칼륨(K), 염소(Cl)
- 정상 수치
- Na: 135~145 mEq/L
- K: 3.5~5.1 mEq/L
- Cl: 98~106 mEq/L
⑦ 염증 지표 (CRP, ESR)
- 검사 목적: 급성 또는 만성 염증 확인
- 정상 수치
- CRP: 0.0~0.5 mg/dL
- ESR: 남성 0
15 / 여성 020 mm/hr
⑧ 종양 표지자 검사 (선택 항목)
- 검사 목적: 특정 암의 존재 가능성 확인
- 대표 항목
- AFP (간암), CEA (대장암), CA 19-9 (췌장암), PSA (전립선암)
혈액검사 결과 해석 방법
혈액검사 결과를 볼 때는 기준치의 ‘범위’에서 벗어났는지가 중요합니다. 단, 수치가 높다고 무조건 병이 있다는 의미는 아니며, 반복 검사와 전문의의 소견이 필요합니다.
예를 들어,
- AST, ALT 수치 상승: 과음, 지방간, 간염 가능성
- HbA1c 상승: 당뇨 가능성
- LDL 수치 상승: 고지혈증, 심혈관질환 위험
혈액검사 준비 시 유의사항
- 공복 유지: 최소 8~12시간 금식
- 약물 중단 여부: 복용 약에 따라 사전 안내 필요
- 운동 자제: 검사 전 과도한 운동은 피할 것
혈액검사로 알 수 있는 주요 질환
| 검사 항목 | 관련 질환 |
| CBC | 빈혈, 백혈병, 감염 |
| 간기능 | 간염, 지방간, 간경화 |
| 신장기능 | 신부전, 신장염 |
| 혈당 | 당뇨병, 공복혈당장애 |
| 지질 | 고지혈증, 동맥경화 |
| 전해질 | 탈수, 신장질환 |
| CRP, ESR | 염증성 질환, 자가면역질환 |
| 종양표지자 | 간암, 대장암, 전립선암 등 |
혈액검사 관련 FAQ
Q1. 혈액검사는 얼마나 자주 받아야 하나요?
👉 특별한 질환이 없더라도 1년에 1회 정기 건강검진을 권장합니다.
Q2. 혈액검사만으로 병을 진단할 수 있나요?
👉 혈액검사는 질환의 가능성을 확인하는 참고 자료입니다. 필요 시 영상검사나 조직검사 등이 추가로 시행됩니다.
Q3. 혈액검사 수치가 정상이어도 안심해도 될까요?
👉 수치가 정상이어도 증상이 있다면 다른 검사를 병행해야 합니다.
혈액검사는 몸 상태를 정확히 파악할 수 있는 가장 기본적이면서도 강력한 건강 진단 도구입니다. 각 항목의 의미를 알고 꾸준히 관리한다면, 질병을 조기에 발견하고 건강을 지키는 데 큰 도움이 됩니다.
정기적인 검진과 함께, 자신의 검사 결과를 이해하고 적극적으로 건강 관리를 시작해 보세요.
'건강' 카테고리의 다른 글
| 기초대사량 높이는 방법, 다이어트 성공의 핵심 꿀팁 (3) | 2025.05.22 |
|---|---|
| 비타민D 부족 증상, 결핍으로 생길 수 있는 질병 총정리 (2) | 2025.05.21 |
| 케겔운동 제대로 하는 법, 여성의 질 건강을 위한 케겔운동 효과 (2) | 2025.05.20 |
| 안구 건조증 원인과 치료법, 인공눈물 추천 및 사용법 (4) | 2025.05.20 |
| 디톡스 주스 효능과 부작용, 올바른 섭취법 총정리 (2) | 2025.05.20 |